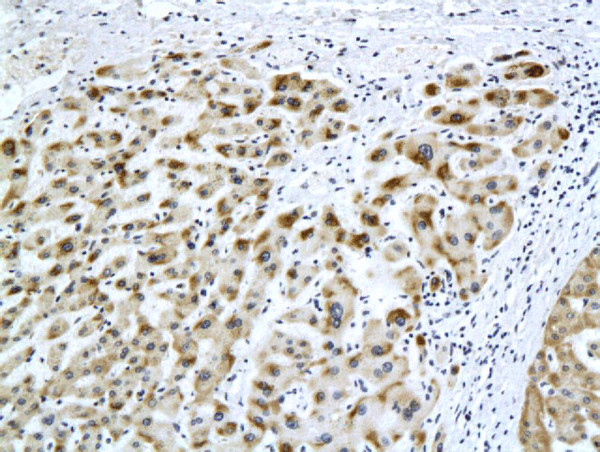
HBsAg Antibody in Immunohistochemistry (Paraffin) (IHC (P))

Search
Bioss
HBsAg Monoclonal Antibody (H2F4)
{{$productOrderCtrl.translations['antibody.pdp.commerceCard.promotion.promotions']}}
{{$productOrderCtrl.translations['antibody.pdp.commerceCard.promotion.viewpromo']}}
{{$productOrderCtrl.translations['antibody.pdp.commerceCard.promotion.promocode']}}: {{promo.promoCode}} {{promo.promoTitle}} {{promo.promoDescription}}. {{$productOrderCtrl.translations['antibody.pdp.commerceCard.promotion.learnmore']}}
产品信息
BSM-2024M
种属反应
宿主/亚型
分类
类型
克隆号
抗原
偶联物
形式
浓度
纯化类型
保存液
内含物
保存条件
运输条件
靶标信息
The hepatitis B virus is an important cause of acute and chronic liver disease. It is also the most common form of parenterally transmitted viral hepatitis. The virus is estimated to affect some 350 million people worldwide. Immunization against hepatitis B is an important component of preventative medicine and is offered to all children in approximately 30 countries. Hepatitis B virus (HBV) belongs to the Hepadnaviridae family and infection with HBV is usually more serious than infection with hepatitis A virus. In some individuals the infection is not cleared and followed by persistent intracellular viral carriage that can lead to the development of hepatocelular carcinomas. There are currently 400 million HBV carriers worldwide making HBV one of the most common human pathogens.
仅用于科研。不用于诊断过程。未经明确授权不得转售。